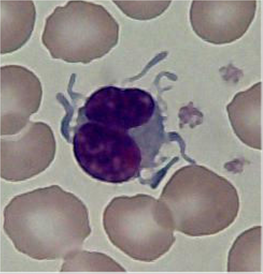

Cytoplasmic Blebs
Created 18 December 2019. Last update 23 January
2021 (Incorporated original blog entry and much new material to new format)
What are blebs?

The literature on cytoplasmic
blebbing is rather difficult to understand (isn't it all?) but it would seem that blebbing is connected with cell movement.Blebs are protrusions of the cell membrane as a
result of actomyosin contractions of the cortex, which cause either transient
detachment of the cell membrane from the actin cortex or a rupture in the actin
cortex. In either event cytosol streams out of the cell body and inflates the
newly formed bleb.
During the expansion, which lasts
only a few second, the bleb is devoid of actin and the surface area increases
through further tearing of membrane from the cortex and convective flows of
lipids in the plane of the membrane through the bleb neck. Once expansion
slows, an actin cortex is reconstituted. First actin‐membrane linker proteins, such as
ezrin, are recruited to the bleb, then actin, actin‐bundling proteins and finally myosin
motor proteins.

Retraction takes longer - a couple of
minutes and is powered by myosin motor proteins. Though it has been less
studied than other actin‐based membrane protrusions such as lamellipodia or
filopodia, blebbing is a common feature of cell physiology during cell
movement, cytokinesis, cell spreading and also in
apoptosis.
The implicaion
is that blebbing are a benign feature... is this true?
The protrusions of blebs should not
be confused with those of hairy cells which are *not* benign.

The size of the blebs can vary.
Here’s some blebs I saw ten years ago. This
was in one isolated cell, and although the cell doesn’t
look benign, nothing like it was seen in the rest of the blood film, nor did
anything appear in repeat samples from that patient.
Some More Expert Opinion…
My
blog entry on those impressive blebs
Wikipedia’s take on
the matter